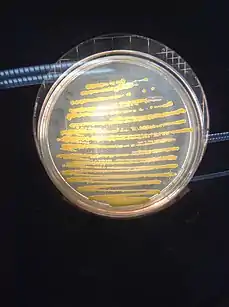

Pili (entreprise)
Pili est une entreprise française spécialisée en biotechnologie[1]. Cette société, créée en 2015 par Jérémie Blache, Guillaume Boissonnat, Marie-Sarah Adenis et Thomas Landrain, a pour but de développer des encres industrielles écologiques et produites par des micro-organismes[2]. Ces encres sont entièrement biodégradables grâce aux pigments fabriqués par des bactéries via la synthèse biologique par fermentation[3]. Le but de cette entreprise est de remplacer les colorants pétrochimiques qui sont excessivement polluants à produire et qui détruisent les écosystèmes[4].
| Pili | |
| Création | 2015 |
|---|---|
| Fondateurs | Jérémie Blache, Marie-Sarah Adenis, Thomas Landrain, Guillaume Boissonnat |
| Siège social | Paris et Toulouse |
| Activité | Biotechnologie |
| Partenaires | La Paillasse, Génopole, Indie Bio, Toulouse White Biotech, Techtera |
Historique
En 2012, la designeuse Marie-Sarah Adenis et le biologiste, Thomas Landrain réalisent l'impact polluant des encres et décident de créer le prototype d'un stylo semi-vivant et autonome dans sa production d'encre[5]. C'est à La Paillasse (Paris), un réseau de laboratoires interdisciplinaires[6], qu'ils tentent de réaliser ce projet. Après de nombreux essais infructueux, ils arrivent à une première version d'un colorant bleu secrété par une bactérie particulière. Ce prototype de stylo est donc composé de bactéries productrices de colorant qu'il faut nourrir pour obtenir de l'encre de manière infinie. C'est ce projet qui est à l'origine de l'entreprise Pili.
La start-up Pili voit le jour en 2015 créée par Jérémie Blache, Guillaume Boissonnat, Marie-Sarah Adenis et Thomas Landrain spécialistes en biologie, en chimie verte, en finance et en design[7]. Elle est basée dans le laboratoire La Paillasse Paris pour la partie chimie et à l'accélérateur Toulouse White Biotech pour le travail de biologie.
Technologie
Pili base sa technologie sur les enzymes et conçoit des circuits enzymatiques pour des sources de carbone renouvelable en molécules colorantes[8]. Grâce à ces protéines très puissantes et à la synthèse enzymatique, l'entreprise obtient des colorants biomatériaux à partir de sources de carbone renouvelables comme le sucre, déchets agricoles et autres nutriments. Au départ, l'entreprise obtient uniquement un colorant bleu mais grâce à la spécificité et l’efficacité des enzymes, elle développe aujourd'hui plusieurs couleurs adaptables à diverses applications.
Afin de développer le projet à grande échelle, les enzymes sont intégrées dans des micro-organismes tels que les bactéries. Elles se développent dans l'eau à température ambiante. Le sucre est utilisé comme matière première renouvelable et ce processus de "bio-fabrique" ne génère aucun sous-produit polluant[9].

Pour réaliser ce processus biologique durable, les bactéries sont cultivées par procédés de fermentation dans des bioréacteurs. Une fois le processus terminé, les pigments sont filtrés des bactéries puis purifiés des résidus du milieu de culture. Pour finir, les pigments sont formulés en fonction des différentes applications. Le secteur du textile[10] est privilégié car c'est le principal défi écologique. En effet, il requiert un volume important de colorants.
Concours
En 2016, Pili remporte le concours Circular Challenge[11] organisé par CITEO. C'est un concours dédié aux startups et aux PME afin d'accélérer l'innovation au sein des filières de l'économie circulaire et du recyclage de papiers et d'emballages[12] .
Notes et références
- Aurélie Dureuil, « Colorants : Pili s’installe à Toulouse White Biotech », sur FormuleVerte.com, (consulté le )
- Olivier Barrellier, « Des colorants bio ET industriels avec PILI », sur La Tribune, (consulté le )
- Denis Fainsilber, « PILI, le pionnier de l'encre " bio " », sur L'Écho, (consulté le )
- Emmanuel Moreau, « Elevage de bactéries pour produire la couleur des vêtements ou des encres des cartouches d'imprimantes. », sur France Inter, (consulté le )
- « FAQ », sur Pili (consulté le )
- Marine Miller, « La Paillasse, lieu ovni parisien qui fédère artistes et scientifiques », sur Lemonde.fr, (consulté le )
- Yolande Foltz, « Pili, la startup qui produit des colorants à partir du vivant », sur Les Horizons, (consulté le )
- « Une technologie vivante qui s'appuie sur des usines cellulaires propres et puissantes », sur Pili (consulté le )
- Marina BERTSCH, « Verdir nos couleurs : des teintures textiles renouvelables », sur France 24, (consulté le )
- « Colorer ses vêtements avec des bactéries », sur SOONSOONSOON, (consulté le )
- Citeo, « Pili remporte l'édition 2016 du concours - Circular Challenge », sur Youtube.com, (consulté le )
- « Le programme d’Open Innovation pour une économie circulaire », sur Circular-challence.com (consulté le )
Voir aussi
Articles connexes
Liens externes
- Portail des entreprises
- Portail de l’Île-de-France